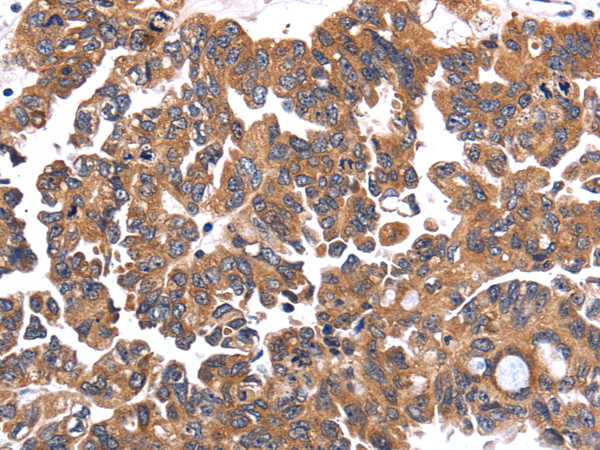

别名:CAIV; Car4; RP17应用:WB,IHC
反应种属:Human, Mouse
规格:50μl/100μl
| Description |
|---|
| Carbonic anhydrases (CAs) are a large family of zinc metalloenzymes that catalyze the reversible hydration of carbon dioxide. They participate in a variety of biological processes, including respiration, calcification, acid-base balance, bone resorption, and the formation of aqueous humor, cerebrospinal fluid, saliva, and gastric acid. They show extensive diversity in tissue distribution and in their subcellular localization. This gene encodes a glycosylphosphatidyl-inositol-anchored membrane isozyme expressed on the luminal surfaces of pulmonary (and certain other) capillaries and proximal renal tubules. Its exact function is not known; however, it may have a role in inherited renal abnormalities of bicarbonate transport. |
| Specification | |
|---|---|
| Aliases | CAIV; Car4; RP17 |
| Swissprot | P22748 |
| WB Predicted band size | 35 kDa |
| Host/Isotype | Rabbit IgG |
| Storage | Store at 4°C short term. Aliquot and store at -20°C long term. Avoid freeze/thaw cycles. |
| Species Reactivity | Human, Mouse |
| Immunogen | Fusion protein of human CA4 |
| Formulation | pH7.4 PBS, 0.05% NaN3, 40% Glycerol |
| Application | |
|---|---|
| WB | 1/500-1/2000 |
| IHC | 1/25-1/100 |
| ELISA | 1/2000-1/5000 |
![]() |
Gel: 8%SDS-PAGE, Lysate: 40 μg, Lane 1-2: Human normal lung and mouse lung tissue , Primary antibody: P07158(CA4 Antibody) at dilution 1/300, Secondary antibody: Goat anti rabbit IgG at 1/8000 dilution, Exposure time: 40 seconds |
![]() |
The image is immunohistochemistry of paraffin-embedded Human ovarian cancer tissue using P07158(CA4 Antibody) at dilution 1/30. (Original magnification: ×200) |
![]() |
The image is immunohistochemistry of paraffin-embedded Human colon cancer tissue using P07158(CA4 Antibody) at dilution 1/30. (Original magnification: ×200) |
本公司的所有产品仅用于科学研究或者工业应用等非医疗目的,不可用于人类或动物的临床诊断或治疗,非药用,非食用。
暂无评论
本公司的所有产品仅用于科学研究或者工业应用等非医疗目的,不可用于人类或动物的临床诊断或治疗,非药用,非食用。
中文

发表回复